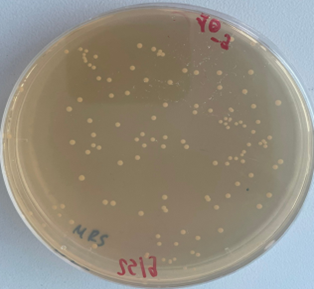
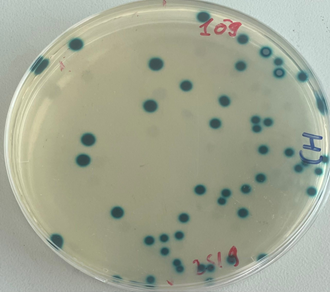

ĐÁNH GIÁ ĐỘC TÍNH CẤP VÀ ĐỘC TÍNH BÁN TRƯỜNG DIỄN CỦA VIÊN NANG CỨNG PROBIOTIC ENTVN 500 MG TRÊN ĐỘNG VẬT THỰC NGHIỆM
Viện Y sinh Nhiệt đới, Trung tâm Nhiệt đới Việt - Nga Số 63 Nguyễn Văn Huyên, Nghĩa Đô, Cầu Giấy, Hà Nội
Số điện thoại: 0948246464; Email: lananhrus@gmail.com
Nội dung chính của bài viết
Tóm tắt (Abstract)
EVALUATION OF ACUTE AND SEMI-CRONIC TOXICITY OF PROBIOTIC ENTVN 500 MG IN EXPERIMENTAL ANIMALS
Probiotic EntVN 500 mg contains the probiotic strains E. faecium F26BA and E. faecium F54BA, both of which were isolated from traditional Vietnamese foods. This study's goal is to evaluate the safety of Probiotic EntVN 500 mg through an acute and semi-chronic toxicity oral administration. Toxicity studies on Wistar rats showed that even at a dose of 10 000 mg/kg body weight-40 times higher than the typical human dose-no 50% mortality rate (LD50) was observed. After administering EntVN Probiotic 500 mg to sewer rat at a daily dose of 140 mg/kg body weight (equivalent to the human dosage) and 420 mg/kg body weight (three times the human dosage) over a four-week period, no significant changes were observed hematological parameters including red blood cells, white blood cells, hemoglobin, hematocrit, and platelets. Blood chemistry tests, measuring levels of AST, ALT, cholesterol, albumin, and creatinine, also showed no significant variations. Additionally, histopathological examinations of the liver, spleen, and kidneys revealed no damage. Mice after using EntVN 500 mg increased their weight slightly compared to the control group. The concentration of viable probiotic bacteria was 3.3 x 1010 CFU/g at the time of production, and 3 x 1010 CFU/g one month later, indicating stable potency. The capsule formulation complies with Vietnam's national standards for bacterial contamination limits and heavy metal contamination limits. The results indicate that the capsule Probiotic EntVN 500 mg ingredients are safe and have potential applications in the field of pharmaceuticals and functional foods.
Từ khóa (Keywords)
độc tính cấp, độc tính bán trường diễn
Chi tiết bài viết
1. ĐẶT VẤN ĐỀ
Viên nang cứng Probiotic EntVN 500 mg chứa chủng vi khuẩn Enterococcus faecium (E. faecium) thuộc nhóm enterococci, là vi khuẩn gram dương, không hình thành bào tử, sinh axit lactic, được ứng dụng nhiều trong các sản phẩm thực phẩm và sản xuất probiotic [1, 2]. Enterococci được nghiên cứu và ứng dụng rộng rãi trong sản xuất probiotic với một số các đặc tính như khả năng tồn tại và phát triển trong đường ruột, dung nạp dịch dạ dày và mật của con người, bám dính tốt vào bề mặt biểu mô, kích thích miễn dịch, hoạt động đối kháng với mầm bệnh đường ruột, khả năng ổn định và điều chỉnh cân bằng hệ vi sinh vật đường ruột [3]. Các lợi ích của enterococci sử dụng trong probiotic đã được chứng minh: có thể ức chế sự bám dính của mầm bệnh trên thành ruột, giảm cholesterol [4, 5]; sử dụng kết hợp trong quá trình điều trị tiêu chảy bằng thuốc kháng sinh, hỗ trợ điều trị nhiễm virus, vi khuẩn gây độc thực phẩm [6]; kiềm chế sự phát triển của vi khuẩn gây bệnh [7]; chống đột biến gen và chống ung thư; phòng ngừa loét liên quan đến nhiễm Helicobacter pylori [8]. Hiện nay, trên thị trường các sản phẩm probiotic có nguồn gốc Việt Nam còn hạn chế, chủ yếu lưu hành các chế phẩm men vi sinh nguồn gốc ngoại nhập [9]. Với mong muốn tìm kiếm và phát triển sản phẩm probiotic từ các lợi khuẩn bản địa phù hợp với hệ tiêu hóa người Việt Nam, nhóm nghiên cứu đã chế tạo sản phẩm Probiotic EntVN 500 mg có 02 thành phần là chủng E. faecium F26BA và E. faecium F54BA, được phân lập từ thực phẩm lên men truyền thống. Trình tự toàn bộ hệ gen các chủng trên được công bố trên cơ sở dữ liệu của Trung tâm Thông tin Công nghệ sinh học Quốc gia Hoa Kỳ (NCBI) với mã là JARGGM000000000 và JARDYX000000000.
Bài báo này trình bày kết quả đánh giá độc tính cấp và độc tính bán trường diễn trên động vật thực nghiệm; các chỉ tiêu an toàn gồm giới hạn nhiễm khuẩn, giới hạn nhiễm kim loại nặng; hàm lượng lợi khuẩn của Probiotic EntVN 500 mg.
2. ĐỐI TƯỢNG VÀ PHƯƠNG PHÁP NGHIÊN CỨU
2.1. Vật liệu nghiên cứu
Chuột nhắt trắng chủng Swiss, khỏe mạnh, trọng lượng 20 ± 2 g do Viện Vệ sinh Dịch tễ Trung ương cung cấp. Chuột cống trắng chủng Wistar, khoẻ mạnh, trọng lượng 180 ± 20 g do Trung tâm Cung cấp Động vật Thí nghiệm Đan Phượng, Hà Nội cung cấp.
Động vật được nuôi dưỡng theo chế độ tiêu chuẩn tại phòng thí nghiệm Viện Kiểm nghiệm, Nghiên cứu Dược và Trang thiết bị Y tế Quân đội từ 3 đến 5 ngày trước khi thực hiện các nghiên cứu và trong suốt thời gian nghiên cứu được ăn bằng thức ăn chuẩn dành riêng cho chuột, uống nước tự do.
Viên nang cứng Probiotic EntVN 500 mg có thành phần: chủng lợi khuẩn E. faecium F26BA và E. faecium F54BA với tỷ lệ sinh khối khô chiếm ~20% tổng khối lượng, mật độ khuẩn lạc >1010CFU/g; đậu nành và tá dược vừa đủ. Sản phẩm được Trung tâm Nhiệt đới Việt - Nga nghiên cứu và phối hợp với Trung tâm Ứng dụng khoa học công nghệ Dược liệu, Viện Dược liệu sản xuất.
2.2. Phương pháp nghiên cứu
2.2.1. Xác định độc tính cấp
Độc tính cấp theo đường uống được xác định bằng phương pháp Behrens-Karber [10]. Chuột đạt yêu cầu được chia thành 5 lô, mỗi lô 10 con và cho nhịn ăn 15 giờ trước khi tiến hành thí nghiệm. Cho chuột uống chế phẩm với liều tăng dần từ 3164 mg/kg đến 10 000 mg/kg với các lô, gấp trên 40 lần liều dùng dự kiến trên người. Theo dõi tình trạng chung và số lượng chuột chết ở mỗi lô trong 72 giờ từ đó xác định LD50. Tiếp tục theo dõi tình trạng của chuột đến hết ngày thứ 7 sau khi uống thử lần đầu.
2.2.2. Xác định độc tính bán trường diễn
Độc tính bán trường diễn được xác định theo hướng dẫn của WHO và OECD trên chuột cống trắng [10, 11, 12]. Chuột cống trắng đạt yêu cầu được chia làm 3 lô, mỗi lô 10 con. Lô chứng: Uống nước cất. Lô trị 1: Uống Probiotic EntVN 500 mg liều 140 mg/kg/ngày (tương đương với liều dùng quy đổi trên người là 0,2x109 CFU/ml/kg/ngày (2 viên/ngày)). Lô trị 2: Uống Probiotic EntVN 500 mg liều 420 mg/kg/ngày. Tất cả chuột được cho uống thuốc mỗi ngày 1 lần vào buổi sáng với thể tích như nhau (1ml/100g/lần), trong 4 tuần. Tiến hành đánh giá tại các thời điểm 0, 2 và 4 tuần sau uống sản phẩm trên các chỉ tiêu: tình trạng chung và thể trọng của chuột; đánh giá chức năng gan thông qua định lượng một số enzym và chất chuyển hóa trong máu: ALT, AST, cholesterol, albumin; đánh giá chức năng thận thông qua định lượng creatinin huyết thanh; đánh giá chỉ số huyết học (hồng cầu, bạch cầu, tiểu cầu hemoglobin và hematocrit); Sau khi kết thúc 4 tuần uống mẫu nghiên cứu, chuột được mổ để quan sát đại thể toàn bộ cơ quan. Tiến hành xét nghiệm vi thể gan, thận, lách ngẫu nhiên của 60% số chuột ở mỗi lô thử nghiệm.
2.2.3. Xác định mật độ lợi khuẩn và đánh giá tính an toàn của chế phẩm
Xác định mật độ lợi khuẩn của viên nang Probiotic EntVN 500 mg sau khi sản xuất và sau 1 tháng sản xuất theo tiêu chuẩn Việt Nam TCVN 8177 [13].
Xác định giới hạn nhiễm khuẩn của viên nang theo TCVN 9633:2013 [14], hàm lượng các kim loại nặng theo TCVN 8126:2009 [15] sau khi sản xuất và sau 1 tháng sản xuất.
2.3. Xử lý thống kê
Các kết quả huyết học, sinh hóa được biểu diễn dưới dạng M ± SD (M là trung bình của từng lô, SD: là độ lệch chuẩn). Sử dụng phương pháp thống kê sinh học bằng phần mềm SPSS 20.0, kiểm định bằng Paired Samples Correlations. Sự khác biệt có ý nghĩa thống kê khi p < 0,05.
3. KẾT QUẢ VÀ BÀN LUẬN
3.1. Độc tính cấp
Theo số liệu Bảng 1, các lô chuột uống thuốc thử theo liều tăng dần từ 3164 mg/kg đến 10 000 mg/kg, gấp 40 lần liều dùng dự kiến trên người. Không nhận thấy biểu hiện ngộ độc nào trên chuột thí nghiệm trong thời gian theo dõi, chuột hoạt động bình thường, các biểu hiện sinh lý bình thường. Sau 72 giờ, các lô chuột thí nghiệm đều không có chuột chết. Vì vậy chưa xác định được LD50 của viên nang cứng Probiotic EntVN 500 mg.
Bảng 1. Kết quả nghiên cứu độc tính cấp của Probiotic EntVN 500 mg
Nhóm | Số chuột TN | Thể tích uống (ml hỗn dịch/10 g thể trọng) | Liều lượng tương ứng (mg/kg/ngày) | Nồng độ (mg/100 ml) | Số chuột chết |
Lô 1 | 10 | 0,2 | 3 164 | 15 820 | 0/10 |
Lô 2 | 10 | 0,2 | 4 219 | 21 090 | 0/10 |
Lô 3 | 10 | 0,2 | 5 625 | 28 130 | 0/10 |
Lô 4 | 10 | 0,2 | 7 500 | 37 500 | 0/10 |
Lô 5 | 10 | 0,2 | 10 000 | 50 000 | 0/10 |
3.2. Độc tính bán trường diễn
Trong thời gian thí nghiệm, tất cả các chuột đều hoạt động bình thường, ăn uống tốt, phân khô, lông mượt. Chuột không có biểu hiện khác thường. Sau 2 tuần và 4 tuần uống viên nang cứng Probiotic EntVN 500 mg, trọng lượng chuột ở cả 3 lô (lô chứng và 2 lô dùng hỗn dịch viên nang cứng Probiotic EntVN 500 mg) đều tăng và có ý nghĩa thống kê so với trước nghiên cứu. Không có sự khác biệt về mức độ gia tăng trọng lượng chuột giữa lô chứng và các lô trị tại cùng thời điểm (p > 0,05) (Bảng 2).
Bảng 2. Ảnh hưởng của EntVN 500 mg đến thể trọng chuột
Thời gian | Trọng lượng trung bình chuột TB ± SD (gam) | p | ||
Lô chứng | Lô trị 1 | Lô trị 2 | ||
Trước uống | 188,30 ± 8,42 | 190,16 ± 6,88 | 190,30 ± 8,65 | p0-1, p0-2>0,05 |
Sau 2 tuần | 222,30 ± 6,74 | 226,20 ± 10,28 | 224,15 ± 5,61 | p0-1, p0-2>0,05 |
p (trước-sau) | p < 0,05 | p < 0,05 | p < 0,05 |
|
Sau 4 tuần | 242,15 ± 4,08 | 245,70 ± 5,01 | 244,80 ± 6,92 | p0-1, p0-2>0,05 |
p (trước-sau) | p < 0,05 | p < 0,05 | p < 0,05 |
|
Đánh giá về sự ảnh hưởng của chế phẩm tới chức năng tạo máu, nhận thấy sau 2 tuần và 4 tuần cho chuột uống viên nang cứng Probiotic EntVN 500 mg, các chỉ số hồng cầu, bạch cầu, tiểu cầu và hàm lượng hemoglobin, hematocrit trong máu chuột ở lô trị 1, lô trị 2 thay đổi không có ý nghĩa thống kê (p > 0,05) so với lô chứng. Không có sự khác biệt về chỉ số hồng cầu, bạch cầu, tiểu cầu và hàm lượng hemoglobin, hematocrit trong máu chuột giữa lô chứng và lô dùng chế phẩm tại cùng thời điểm (p > 0,05) (Bảng 3).
Bảng 3. Ảnh hưởng của EntVN 500 mg đến số lượng hồng cầu, bạch cầu, tiểu cầu và hàm lượng hemoglobin, hematocrit trong máu chuột
Chỉ số NC | Thời điểm NC | Lô chứng (n = 10) | Lô trị 1 (n = 10) (140 mg/kg/ngày) | Lô trị 2 (n = 10) (420 mg/kg/ngày) | p |
|---|---|---|---|---|---|
Hồng cầu (1012/L) | N 0 | 8,63 ± 0,73 | 8,51 ± 0,95 | 8,50 ± 0,85 | p0-1, p0-2, p1-2 >0,05 |
N 14 | 8,64 ± 0,61 | 8,53 ± 0,82 | 8,53 ± 0,73 | p0-1, p0-2, p1-2 >0,05 | |
p0-14 | > 0,05 | > 0,05 | > 0,05 |
| |
N 28 | 8,66 ± 0,76 | 8,54 ± 1,00 | 8,55 ± 0,70 | p0-1, p0-2, p1-2 >0,05 | |
p0,14-28 | > 0,05 | > 0,05 | > 0,05 |
| |
Bạch cầu (109/L) | N 0 | 7,64 ± 2,19 | 7,32 ± 1,63 | 7,29 ± 1,37 | p0-1, p0-2, p1-2 >0,05 |
N 14 | 7,65 ± 2,19 | 7,36 ± 1,64 | 7,20 ± 1,20 | p0-1, p0-2, p1-2 >0,05 | |
p0-14 | > 0,05 | > 0,05 | > 0,05 |
| |
N 28 | 7,74 ± 1,74 | 7,72 ± 1,53 | 7,77 ± 1,95 | p0-1, p0-2, p1-2 >0,05 | |
p0,14-28 | > 0,05 | > 0,05 | > 0,05 |
| |
Tiểu cầu (109/L) | N 0 | 481,00 ± 84,79 | 487,20 ± 112,30 | 480,80 ± 93,25 | p0-1, p0-2, p1-2 >0,05 |
N 14 | 481,40 ± 59,71 | 478,00 ± 150,58 | 484,40 ± 162,80 | p0-1, p0-2, p1-2 >0,05 | |
p0-14 | > 0,05 | > 0,05 | > 0,05 |
| |
N 28 | 481,20 ± 60,59 | 482,40 ± 52,50 | 486,40 ± 127,19 | p0-1, p0-2, p1-2 >0,05 | |
p0,14-28 | > 0,05 | > 0,05 | > 0,05 |
| |
Hemoglobin (G/L) | N0 | 179,80 ± 15,02 | 175,60 ± 17,24 | 183,20 ± 20,47 | p0-1, p0-2, p1-2 >0,05 |
N 14 | 180,00 ± 12,06 | 181,10 ± 26,08 | 182,90 ± 14,95 | p0-1, p0-2, p1-2 >0,05 | |
p0-14 | > 0,05 | > 0,05 | > 0,05 |
| |
N 28 | 180,20 ± 12,38 | 177,60 ± 20,00 | 179,60 ± 19,66 | p0-1, p0-2, p1-2 >0,05 | |
p0,14-28 | > 0,05 | > 0,05 | > 0,05 |
| |
Hematocrit (%) | N 0 | 48,92 ± 3,37 | 48,40 ± 5,19 | 49,22 ± 4,49 | p0-1, p0-2, p1-2 >0,05 |
N 14 | 48,95 ± 3,29 | 49,18 ± 8,39 | 49,14 ± 3,14 | p0-1, p0-2, p1-2 >0,05 | |
p0-14 | > 0,05 | > 0,05 | > 0,05 |
| |
N 28 | 48,92 ± 3,68 | 48,67 ± 3,38 | 50,51 ± 6,47 | p0-1, p0-2, p1-2 >0,05 | |
p0,14 -28 | > 0,05 | > 0,05 | > 0,05 |
|
* N0: trước khi cho uống, N14: ngày uống thứ 14, N28: ngày uống thứ 28.
Đánh giá sự thay đổi đối với chức năng gan thông qua hoạt độ ALT, AST và nồng độ cholesterol trong máu chuột ở lô trị 1 và lô trị 2, nhận thấy sự thay đổi không có ý nghĩa thống kê (p > 0,05) so với lô chứng sau 2 tuần và 4 tuần cho chuột uống viên nang cứng Probiotic EntVN 500 mg. Không có sự khác biệt hoạt độ ALT, AST và nồng độ cholesterol toàn phần trong máu chuột giữa lô chứng và lô dùng chế phẩm tại cùng thời điểm (p > 0,05) (Bảng 4).
Bảng 4. Ảnh hưởng của EntVN 500 mg đến hoạt độ ALT, AST và nồng độ cholesterol toàn phần trong máu chuột
Chỉ số NC | Thời điểm NC | Lô chứng (n = 10) | Lô trị 1 (n = 10) (140 mg/kg/ngày) | Lô trị 2 (n = 10) (420 mg/kg/ngày) | p |
|---|---|---|---|---|---|
ALT (U/L) | N 0 | 96,90 ± 26,33 | 101,50 ± 18,33 | 99,00 ± 14,67 | p0-1, p0-2, p1-2 >0,05 |
N 14 | 97,00 ± 21,72 | 97,40 ± 28,00 | 96,70 ± 17,49 | p0-1, p0-2, p1-2 >0,05 | |
p0-14 | > 0,05 | > 0,05 | > 0,05 |
| |
N 28 | 97,00 ± 36,27 | 101,50 ± 21,28 | 98,10 ± 35,23 | p1-2 >0,05 | |
p0,14-28 | > 0,05 | > 0,05 | > 0,05 |
| |
AST (U/L) | N 0 | 128,40 ± 24,36 | 128,80 ± 22,75 | 129,40 ± 33,54 | p0-1, p0-2, p1-2 >0,05 |
N 14 | 128,20 ± 41,43 | 131,80 ± 25,80 | 130 ± 20,35 | p0-1, p0-2, p1-2 >0,05 | |
p0-14 | > 0,05 | > 0,05 | > 0,05 |
| |
N 28 | 128,50 ± 13,45 | 130,50 ± 21,77 | 130,70 ± 29,65 | p0-1, p0-2, p1-2 >0,05 | |
p0,14-28 | > 0,05 | > 0,05 | > 0,05 |
| |
Cholesterol (mmol/l) | N 0 | 1,65 ± 0,17 | 1,67 ± 0,13 | 1,68 ± 0,11 | p0-1, p0-2, p1-2 >0,05 |
N 14 | 1,66 ± 0,18 | 1,68 ± 0,15 | 1,69 ± 0,15 | p0-1, p0-2, p1-2 >0,05 | |
p0-14 | > 0,05 | > 0,05 | > 0,05 |
| |
N 28 | 1,67 ± 0,25 | 1,68 ± 0,17 | 1,70 ± 0,17 | p0-1, p0-2, p1-2 >0,05 | |
p0,14-28 | > 0,05 | > 0,05 | > 0,05 |
|
* N0: trước khi cho uống, N14: ngày uống thứ 14, N28: ngày uống thứ 28.
Sau 2 tuần và 4 tuần cho chuột uống viên nang cứng Probiotic EntVN 500 mg, nồng độ abumin và creatinin trong máu chuột ở lô trị 1 và lô trị 2 thay đổi không có ý nghĩa thống kê (p > 0,05) so với lô chứng. Không có sự khác biệt nồng độ albumin và creatinin trong máu chuột giữa lô chứng và lô dùng chế phẩm tại cùng thời điểm (p > 0,05) (Bảng 5).
Bảng 5. Ảnh hưởng của EntVN 500 mg đến nồng độ albumin và creatinin
trong máu chuột
Chỉ số NC | Thời điểm NC | Lô chứng (n = 10) | Lô trị 1 (n = 10) (140 mg/kg/ngày) | Lô trị 2 (n = 10) (420 mg/kg/ngày) | p |
|---|---|---|---|---|---|
Albumin (g/L) | N 0 | 34,30 ± 1,34 | 34,00 ± 1,25 | 34,40 ± 0,97 | p0-1, p0-2, p1-2 >0,05 |
N 14 | 34,40 ± 0,97 | 34,30 ± 1,34 | 34,20 ± 1,03 | p0-1, p0-2, p1-2 >0,05 | |
p0-14 | > 0,05 | > 0,05 | > 0,05 |
| |
N 28 | 34,50 ± 1,72 | 34,40 ± 1,96 | 34,30 ± 1,95 | p0-1, p0-2, p1-2 >0,05 | |
p0,14-28 | > 0,05 | > 0,05 | > 0,05 |
| |
Creatinin (µmol/l) | N 0 | 74,30 ± 5,98 | 74,10 ± 7,09 | 75,70 ± 3,80 | p0-1, p0-2, p1-2 >0,05 |
N 14 | 75,00 ± 7,56 | 74,70 ± 5,72 | 74,90 ± 4,82 | p0-1, p0-2, p1-2 >0,05 | |
p0-14 | > 0,05 | > 0,05 | > 0,05 |
| |
N 28 | 75,00 ± 4,40 | 75,60 ± 3,57 | 75,20 ± 6,61 | p0-1, p0-2, p1-2 >0,05 | |
p0,14-28 | > 0,05 | > 0,05 | > 0,05 |
|
* N0: trước khi cho uống, N14: ngày uống thứ 14, N28: ngày uống thứ 28.
Đánh giá ảnh hưởng của viên nang cứng Probiotic EntVN 500 mg tới sự thay đổi mô bệnh học gan, thận. Quan sát đại thể bằng mắt thường và dưới kính lúp có độ phóng đại 25 lần nhận thấy: màu sắc, hình thái của gan, lách và thận ở 2 lô trị không khác so với lô chứng (Hình 1).
![]() | ![]() | ![]() |
Hình 1. Hình ảnh đại thể gan, thận, lách chuột dưới kính lúp có độ phóng đại 25 lần.A- lô chứng; B- lô trị 1; C- lô trị 2
Quan sát hình ảnh vi thể gan sau 28 ngày uống chế phẩm dưới kính hiển vi với độ khuếch đại 200 lần, nhận thấy hình thái vi thể gan chuột ở cả ba lô (lô chứng, lô trị 1, lô trị 2) không thấy xuất huyết, hoại tử, thoái hóa tế bào gan. Nhu mô gan bình thường (Hình 2).
![]() | ![]() | ![]() |
Hình 2. Vi thể gan chuột dưới kính hiển vi khuếch đại 200 lần sau 28 ngày uống Probiotic EntVN 500 mg. A- lô chứng; B- lô trị 1; C- lô trị 2.
Hình thái vi thể thận, lách chuột ở cả ba lô đều bình thường, không có sự khác biệt so với hình ảnh vi thể thận, lách chuột ở lô chứng. Các tế bào ống thận bắt màu xanh thẫm. Cấu trúc các vùng chức năng thận, lách bình thường (Hình 3, 4).
![]() | ![]() | ![]() |
Hình 3. Vi thể thận chuột dưới kính hiển vi khuếch đại 200 lần sau 28 ngày uống Probiotic EntVN 500 mg. A- lô chứng; B- lô trị 1; C- lô trị 2
![]() | ![]() | ![]() |
Hình 4. Vi thể lách chuột dưới kính hiển vi khuếch đại 200 lần sau 28 ngày uống Probiotic EntVN 500 mg. A- lô chứng; B- lô trị 1; C- lô trị 2
3.3. Xác định mật độ lợi khuẩn và đánh giá tính an toàn của chế phẩm
Kiểm tra mật độ khuẩn lạc của các lợi khuẩn E. faecium tại thời điểm sau khi sản xuất và sau 1 tháng trên môi trường thạch MRS và thạch Chromatic Detection, nhận thấy mật độ khuẩn E. faecium đạt lần lượt là 3,3.1010CFU/g và 3.1010CFU/g, đáp ứng được yêu cầu về sản phẩm probiotic của WHO/FAO là ≥108 CFU/g [1,13].

Hình 5. Mật độ khuẩn lạc trên môi trường thạch Chromatic Detection (A) và MRS (B)
Xác định giới hạn nhiễm khuẩn viên nang cứng Probiotic EntVN 500 mg sau sản xuất theo TCVN9633:2013, không phát hiện nhóm vi sinh vật gây bệnh đường ruột nguy hiểm như Staphylococci dương tính coagulase, Salmonella spp. và Listeria monocytogenes trong mẫu thử. Đây là các tiêu chí bắt buộc đối với các sản phẩm sữa lên men, probiotic [14]. Ngoài ra, không phát hiện hàm lượng kim loại Pb, Cd và Hg trong mẫu thử [15].
Hai chủng lợi khuẩn E. faecium F26BA và E. faecium F54BA là thành phần quan trọng nhất của viên nang cứng Probiotic EntVN 500 mg. Đây là các chủng mới, trước đây chưa ghi nhận trên Trung tâm Thông tin Công nghệ sinh học Quốc gia Hoa Kỳ (NCBI), được nhóm nghiên cứu phân lập được từ thực phẩm lên men truyền thống Việt Nam. Nghiên cứu các đặc tính probiotic tại phòng thí nghiệm, cả hai chủng đều có khả năng kháng một số vi khuẩn gây bệnh phổ biến đường ruột như E. coli, Salmonella, Shigella, có khả năng sống sót trong môi trường dịch mật và độ pH thấp, tương đương với nồng độ trong dạ dày người. Đánh giá tính an toàn trên in vitro, nhận thấy các chủng đều không chứa các gen mã hóa gây độc, không có tính tan huyết, không kháng vancomycin. Phân tích trình tự toàn bộ hệ gen, phát hiện cả hai chủng đều xuất hiện các đoạn gen đặc trưng có khả năng sinh bacterocin. Chúng tôi đã đăng ký thành công trình tự toàn bộ hệ gen của hai chủng trên vào cơ sở dữ liệu của Trung tâm Thông tin Công nghệ sinh học Quốc gia Hoa Kỳ (NCBI) với mã chủng là JARGGM000000000 và JARDYX000000000. Từ những ưu điểm trên, nhóm nghiên cứu đã chọn các chủng trên làm nguyên liệu sản xuất probiotic với mong muốn có được sản phẩm bản địa, phù hợp với người dân Việt Nam. Kết quả đánh giá độc tính cấp, độc tính bán trường diễn và các chỉ tiêu chất lượng viên nang đạt yêu cầu là điều kiện cần có để có thể công bố sản phẩm và đưa vào sử dụng trong thực tế.
4. KẾT LUẬN
Độc tính cấp: Chưa tìm thấy LD50 của viên nang cứng Probiotic EntVN 500 mg theo đường uống trên chuột nhắt trắng. Với mức liều cao nhất 10 000 mg/kg thể trọng/ngày, chưa ghi nhận biểu hiện độc tính cấp.
Độc tính bán trường diễn: Với liều 140 mg/kg (tương đương liều sử dụng) và liều 420 mg/kg thể trọng chuột cống/ngày (gấp 3 lần liều sử dụng), uống liên tục trong 4 tuần, viên nang cứng Probiotic EntVN 500 mg không làm thay đổi chỉ số huyết học (hồng cầu, bạch cầu, huyết sắc tố, hematocrit, tiểu cầu) và sinh hóa máu (AST, ALT, cholesterol, albumin, creatinin), không gây tổn thương mô bệnh học gan, lách, thận. Chuột sau khi dùng viên nang cứng Probiotic EntVN 500 mg đều tăng nhẹ trọng lượng so với lô chứng.
Mật độ lợi khuẩn: Đạt 3,3.1010CFU/g sau khi sản xuất, 3.1010CFU/g sau 1 tháng sản xuất. Viên nang đạt các tiêu chí về giới hạn nhiễm khuẩn và giới hạn nhiễm kim loại nặng theo tiêu chuẩn quốc gia của Việt Nam. Kết quả chỉ ra rằng thành phần viên nang Probiotic EntVN 500 mg an toàn, có tiềm năng ứng dụng trong lĩnh vực dược phẩm, thực phẩm chức năng.
Nhận bài ngày 28 tháng 10 năm 2023
Phản biện xong ngày 22 tháng 11 năm 2023
Hoàn thiện ngày 30 tháng 11 năm 2023
(1) Trung tâm Nhiệt đới Việt - Nga
(2) Trường Đại học Khoa học Tự nhiên, Đại học Quốc gia Hà Nội
(3) Viện Kiểm nghiệm, Nghiên cứu Dược và Trang thiết bị Y tế Quân đội
Liên hệ: Bùi Thị Lan Anh
Viện Y sinh Nhiệt đới, Trung tâm Nhiệt đới Việt - Nga
Số 63 Nguyễn Văn Huyên, Nghĩa Đô, Cầu Giấy, Hà Nội
Điện thoại: 0948246464; Email: lananhrus@gmail.com
Tài liệu tham khảo
1. Suvorov A., Ermolenko E., Alechina G., Chernysh A., Karaseva A., Di Pierro F., Enterococcus as probiotics: what is the advantage, Nutrafoods, 2019, 1:17-25.
DOI 10.17470/NF-019-0003
2. Foulquie Moreno M.R., Sarantinopoulos P., Tsakalidou E., De Vuyst L., The role and application of enterococci in food and health, Int J Food Microbiol., 2006, 106:1-24. DOI: 10.1016/j.ijfoodmicro.2005.06.026
3. Hanchi H., Mottawea W., Sebei K., Hammami R., The genus Enterococcus: Between probiotic potential and safety concerns Anupdate, Front. Microbiol., 2018, 9:1791. DOI: 10.3389/fmicb.2018.01791
4. Davoodvandi A., Marzban H., Goleij P., Sahebkar A., Morshedi K., Rezaei S., Mahjoubin-Tehran M., Tarrahimofrad H., Hamblin M.R., Mirzaei H., Effects of therapeutic probiotics on modulation of microRNAs, Cell Commun. Signal, 2021, 19:1-22. https://doi.org/10.1186/s12964-020-00668-w
5. Zhang F., Qiu L., Xu X., Liu Z., Zhan H., Tao X., Shah N. P., Wei H., Beneficial effects of probiotic cholesterol-lowering strainof Enterococcus faecium WEFA23 from infants on diet-induced metabolic syndrome in rats, J. Dairy Sci., 2017, 100:1618-1628. DOI: 10.3168/jds.2016-11870
6. Lau C. S., and Chamberlain R. S., Probiotics are effective at preventing Clostridium difficile-associated diarrhea: a systematic review and meta-analysis, Int. J. Gen. Med., 2016, 9:27-37. DOI: 10.2147/IJGM.S98280
7. Zorriehzahra M. J., Delshad S. T., Adel M., Tiwari R., Karthik K., Dhama K., Probiotics as beneficial microbes in aquaculture: an update on theirmultiple modes of action: a review, Vet. Q., 2016, 36:228-241. DOI: 10.1080/01652176.2016.1172132
8. Oh B., Kim B. S., Kim J. W., Kim J. S., Koh S. J., Kim B. G., The effect of probiotics on gut microbiota during the Helicobacter pylori eradication: randomized controlled trial, Helicobacter, 2016, 21:165-174. DOI: 10.1111/hel.12270
9. Serio A., Chaves-López C., Paparella A., and Suzzi G., Evaluation of metabolic activities of enterococci isolated from Pecorino Abruzzese cheese, Int. Dairy J., 2010, 20:459-464. https://doi.org/10.1016/j.idairyj.2010.02.005
10. Đỗ Trung Đàm, Phương pháp xác định độc tính của thuốc, Nhà xuất bản Y học, Hà Nội, 2014: 184-215.
11. OECD 423, OECD guideline for testing of chemicals - Acute oral toxicity, Acute toxic class method, 2001. https://doi.org/10.1787/9789264071001-en
12. World Health Organization, General guidelines for methodologies on research and evaluation of traditional medicine, 2000.
13. TCVN 8177 (ISO 7889), Sữa chua - định lượng các vi sinh vật đặc trưng - kỹ thuật đếm khuẩn lạc ở 37oC.
14. TCVN 9633:2013 (ISO 27205:2010), Sản phẩm sữa lên men - giống vi khuẩn khởi động - tiêu chuẩn nhận dạng.
15. TCVN 8126:2009, Thực phẩm - xác định chì, cadimi, kẽm, đồng và sắt - phương pháp quang phổ hấp thụ nguyên tử sau khi đã phân hủy bằng vi sóng.











